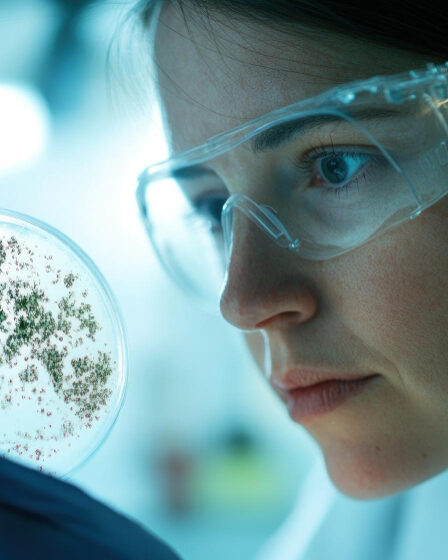

La stimulation cérébrale profonde (SCP) est une intervention neurochirurgicale qui a révolutionné le traitement des tremblements essentiels (TE), particulièrement chez les patients dont les symptômes sont réfractaires aux traitements médicamenteux conventionnels. Depuis son introduction, la SCP a fait l’objet de nombreuses études et essais cliniques visant à affiner ses techniques, à améliorer ses résultats et …
Blog
Les Mécanismes Neuropathologiques des Tremblements Essentiels : Synthèse des Études Récentes
Les tremblements essentiels (TE) sont l’un des troubles du mouvement les plus courants, affectant des millions de personnes dans le monde. Bien que souvent considérés comme bénins, les tremblements essentiels peuvent avoir un impact significatif sur la qualité de vie, rendant les activités quotidiennes difficiles. Comprendre les mécanismes neuropathologiques sous-jacents à cette affection est crucial …
Les Protocoles Expérimentaux pour la Recherche sur les Tremblements Essentiels : Modèles Animaux et Humains
Les tremblements essentiels (TE) sont un trouble neurologique complexe dont les mécanismes sous-jacents restent mal compris. Pour approfondir la compréhension de cette condition et développer des traitements efficaces, des protocoles expérimentaux sophistiqués sont utilisés dans la recherche. Ces protocoles incluent des modèles animaux et humains, chacun offrant des perspectives uniques. Cet article examine en détail …
Biomarqueurs Prédictifs des Réponses au Traitement des Tremblements Essentiels
Les tremblements essentiels (TE) représentent un trouble du mouvement complexe dont le traitement peut varier considérablement en termes d’efficacité d’un patient à l’autre. L’identification de biomarqueurs prédictifs des réponses au traitement pourrait révolutionner la prise en charge de cette maladie en permettant une personnalisation des thérapies. Cet article explore les avancées récentes dans la recherche …
Rôle de la Thalamotomie par Ultrasons Focalisés dans le Traitement des Tremblements Essentiels
Les tremblements essentiels (TE) sont un trouble du mouvement courant qui peut considérablement altérer la qualité de vie des personnes touchées. Lorsque les traitements médicamenteux ne parviennent pas à contrôler les symptômes, des options chirurgicales sont envisagées. Parmi celles-ci, la thalamotomie par ultrasons focalisés (FUS, pour « Focused Ultrasound Surgery ») a émergé comme une technique non …
Chirurgie de Stimulation Cérébrale Profonde (SCP) pour les Tremblements Essentiels : Indications, Techniques et Résultats
La stimulation cérébrale profonde (SCP) est une option thérapeutique avancée pour les patients souffrant de tremblements essentiels (TE) résistants aux traitements médicamenteux. Cette technique neurochirurgicale consiste à implanter des électrodes dans des zones spécifiques du cerveau pour moduler l’activité neuronale anormale. Cet article explore en détail les indications, les techniques chirurgicales, et les résultats cliniques …
Pharmacocinétique des Médicaments Utilisés dans le Traitement des Tremblements Essentiels
Les tremblements essentiels (TE) sont un trouble neurologique complexe qui nécessite souvent une approche pharmacologique pour gérer les symptômes. La pharmacocinétique des médicaments utilisés dans le traitement des TE joue un rôle crucial dans leur efficacité et leur tolérance. Cet article explore en détail la pharmacocinétique des principaux médicaments prescrits pour les tremblements essentiels, en …
Neurotransmetteurs et Tremblements Essentiels : Le Rôle du GABA et du Glutamate
Les tremblements essentiels (TE) sont l’un des troubles du mouvement les plus répandus, mais leur étiologie reste encore mal comprise. Parmi les nombreuses hypothèses explorées pour expliquer les TE, les déséquilibres des neurotransmetteurs, en particulier du GABA (acide gamma-aminobutyrique) et du glutamate, jouent un rôle central. Cet article examine en profondeur l’influence de ces deux …
Imagerie Cérébrale dans les Tremblements Essentiels : Innovations et Applications Cliniques
Les tremblements essentiels (TE) sont l’un des troubles du mouvement les plus fréquents, mais leur étiologie reste en grande partie mystérieuse. De plus en plus de recherches suggèrent une composante génétique significative dans l’apparition de cette affection. Cet article explore les découvertes récentes concernant les gènes potentiellement impliqués dans les tremblements essentiels et leur rôle …
Génétique des Tremblements Essentiels : Découverte des Gènes Impliqués
Les tremblements essentiels (TE) sont un trouble neurologique complexe, souvent difficile à diagnostiquer en raison de la variabilité de ses symptômes. L’imagerie cérébrale a émergé comme un outil clé pour améliorer notre compréhension des mécanismes sous-jacents des TE, ainsi que pour affiner les stratégies de diagnostic et de traitement. Cet article explore les innovations récentes …